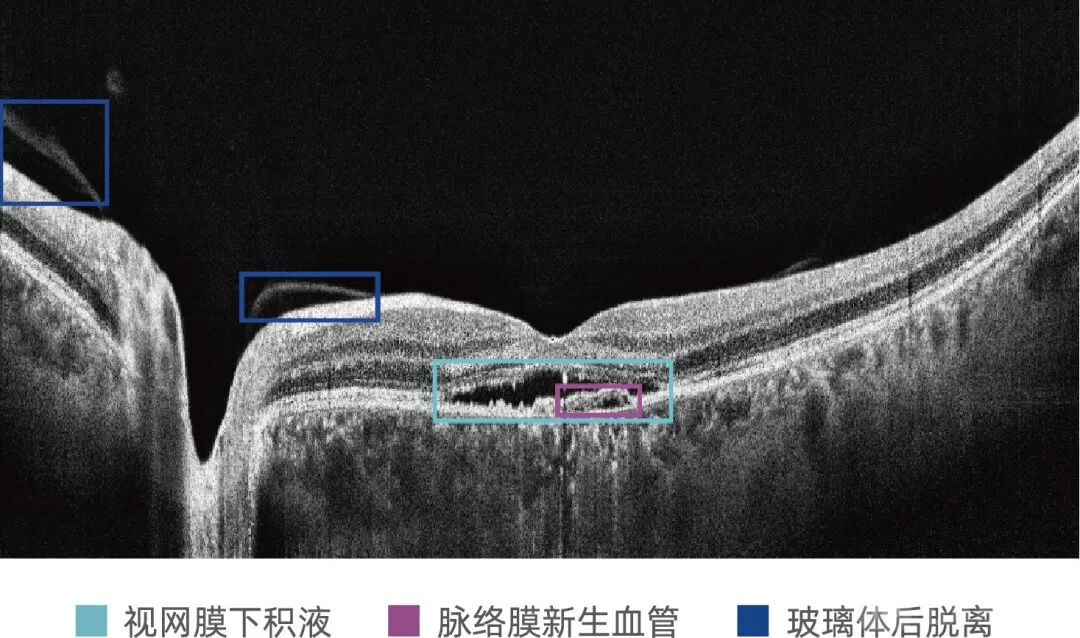
1762770193244712.png 1762770193244712.png

10月27日,苏州比格威医疗科技有限公司自主研发的“眼科OCT图像辅助诊断软件MIAS-3000”正式获得国家药品监督管理局颁发的三类医疗器械注册证(注册证号:20253212107),标志着AI在眼科复杂影像诊断中正式拥有临床“发言权”。

该证书具有里程碑意义——不仅是国内,更是全球首张针对OCT影像的人工智能辅助诊断系统三类证。在医疗器械监管体系中,三类证属于最高级别,表明该产品的安全性与有效性已达到直接用于临床诊断的标准。这意味着AI不再仅是辅助阅片的工具,而是能够在OCT这类复杂影像诊断中承担实质性诊断职能。
一、跨越门槛:从“辅助阅片”迈向“辅助诊断”
在医疗器械分类中,二类与三类的区别,往往代表了“辅助”与“诊断”的分界线。
过去几年,国内获批的眼科AI产品多属二类医疗器械,主要应用于二维眼底彩照的筛查与风险提示。这类系统的临床定位仍是辅助工具——可提示病灶、标注区域、生成报告,但最终诊断仍需医生确认。
而MIAS-3000作为三类医疗器械,其输出结果不再被视为“参考意见”,而是可在临床诊断决策中承担实质性作用。这要求系统必须在算法稳定性、临床一致性与结果可追溯性方面通过更为严格的验证——不仅要证明“识别准确”,更要确保“持续准确”,并能够解释其判断逻辑。
二、技术突破:从二维到三维的算法跨越
MIAS-3000的核心技术突破在于实现了从“二维”到“三维”的跃升。当前市场上多数眼科AI产品基于二维眼底彩照进行分析,而MIAS-3000直接处理的是OCT三维体数据,其算法基于卷积神经网络(CNN)的深度学习框架,与国际前沿研究方向一致。
1.精准量化分析
系统可对视网膜OCT图像进行逐帧分析,精准识别如大玻璃膜疣(直径≥125μm)等典型病灶。算法不仅需识别病灶存在,还需完成精确量化测量,为疾病进展监测提供客观依据。
2.架构创新
最新研究趋势将CNN与Swin Transformer相结合,构建双分支架构,同步获取图像局部细节与全局上下文信息,显著提升对微小病灶的识别精度。
3.针对中国人群优化
算法训练数据全部来源于中国不同地区的医院临床影像,确保对中国人群的适用性。所有OCT图像均由特定型号(BV1000)的眼科光学相干断层扫描仪在大视野区域扫描模式下采集。
三、临床价值:高效且可靠的诊断表现
MIAS-3000的临床评价基于一项前瞻性、多中心、单组目标设计的临床试验。该试验旨在评估软件辅助阅片与医生单独阅片之间的性能差异。研究共纳入908例受试者,收集有效眼位超过1700只。
1.高精度与高一致性
试验结果显示,在单人单眼层面,软件的灵敏度达95.5%,特异度为92.1%,与医生诊断的一致率为94.7%(Kappa值0.86)。尤其值得关注的是,对需紧急治疗的新生血管性年龄相关性黄斑变性(湿性AMD)的灵敏度高达98.04%,意味着几乎不会漏诊,对防止患者视力永久丧失具有关键意义。
2.提升诊断效率
临床验证表明,该软件可显著缩短医生平均阅片时间。类似研究(如陈浩宇教授团队)证实,AI模型可将眼科医生撰写报告的时间减少近60%,极大释放医生生产力。
四、行业背景:缓解眼科资源分布不均
中国眼病患者数量超过7亿。随着社会老龄化加剧和生活方式的改变,年龄相关性黄斑变性、糖尿病视网膜病变等眼底疾病已成为首要致盲原因。
我国眼科医疗资源总量不足且分布不均,OCT操作与阅片均依赖经验丰富的专业医师,导致基层眼底病OCT筛查覆盖率严重不足。
比格威医疗采取“软硬一体”策略,将AI诊断系统嵌入全自动OCT设备,降低操作门槛与成本,使边疆地区、区县级及基层医院、视光中心与体检机构均可开展精准眼底筛查,构建覆盖“筛查—诊断—治疗—随访”的眼健康全周期智能管理生态。
此前,比格威医疗自主研发的全自动人工智能OCT BV1000已在全国800余家医疗机构投入使用,服务超过60万人次,为缓解我国眼科医疗资源不足提供了有效的技术解决方案。
五、未来路径:机遇与挑战并存
首张三类证的获批开启了AI医疗的新篇章,但未来发展仍面临多重机遇与挑战。
1.商业化落地与支付机制
报告显示,全球眼科AI-OCT市场正以11.2%的年复合增长率扩张。产品获批后,如何制定合理的医疗服务定价与医保支付政策,成为其在各级医疗机构(尤其是基层)广泛推广的关键。
2.技术迭代与临床融合
走向开放集与提升可靠性:未来AI模型需从当前“闭合集”(仅识别训练过的疾病)向“开放集”演进,能够识别并拒绝对未知病变或低质量图像的判断,FMUE模型正是该方向的前沿探索。
从辅助诊断到自动报告:研究团队已开发出可自动生成完整OCT诊断报告的模型MORG,在专家盲评中获得的评分与眼科医生报告相当,预示着AI将进一步深入诊疗核心流程。
软硬一体与平台化:陈新建教授团队采用的“软硬一体”策略,将AI系统与OCT硬件深度融合,降低基层使用门槛。同时,OCT设备正从单纯影像设备向数字化节点演进,对数据接口与科研扩展性的要求不断提高。
3.应对真实世界挑战
AI模型在真实临床环境中可能遭遇训练数据之外的情况(分布外数据)。如何确保其在长期、复杂的临床使用中保持稳定与可靠,是未来需持续关注与验证的课题。
总结
全球首张眼科OCT-AI三类证的获批,标志着中国在眼科AI这一细分赛道实现了从“跟跑”到“领跑”的跨越。这不仅是一款软件的获批,更是对AI在医疗核心环节中角色的重新定义。随着技术与临床实践的深度融合不断推进,眼科AI有望真正成为赋能各级医生、惠及广大患者的可靠力量,重塑眼科疾病的诊疗模式。
声明:本文仅供医疗卫生专业人士学术交流,不代表本平台观点。该等信息不能以任何方式取代专业的医疗指导,也不应被视为诊疗建议,如果该信息用于资讯以外的目的,本平台及作者不承担相关责任。